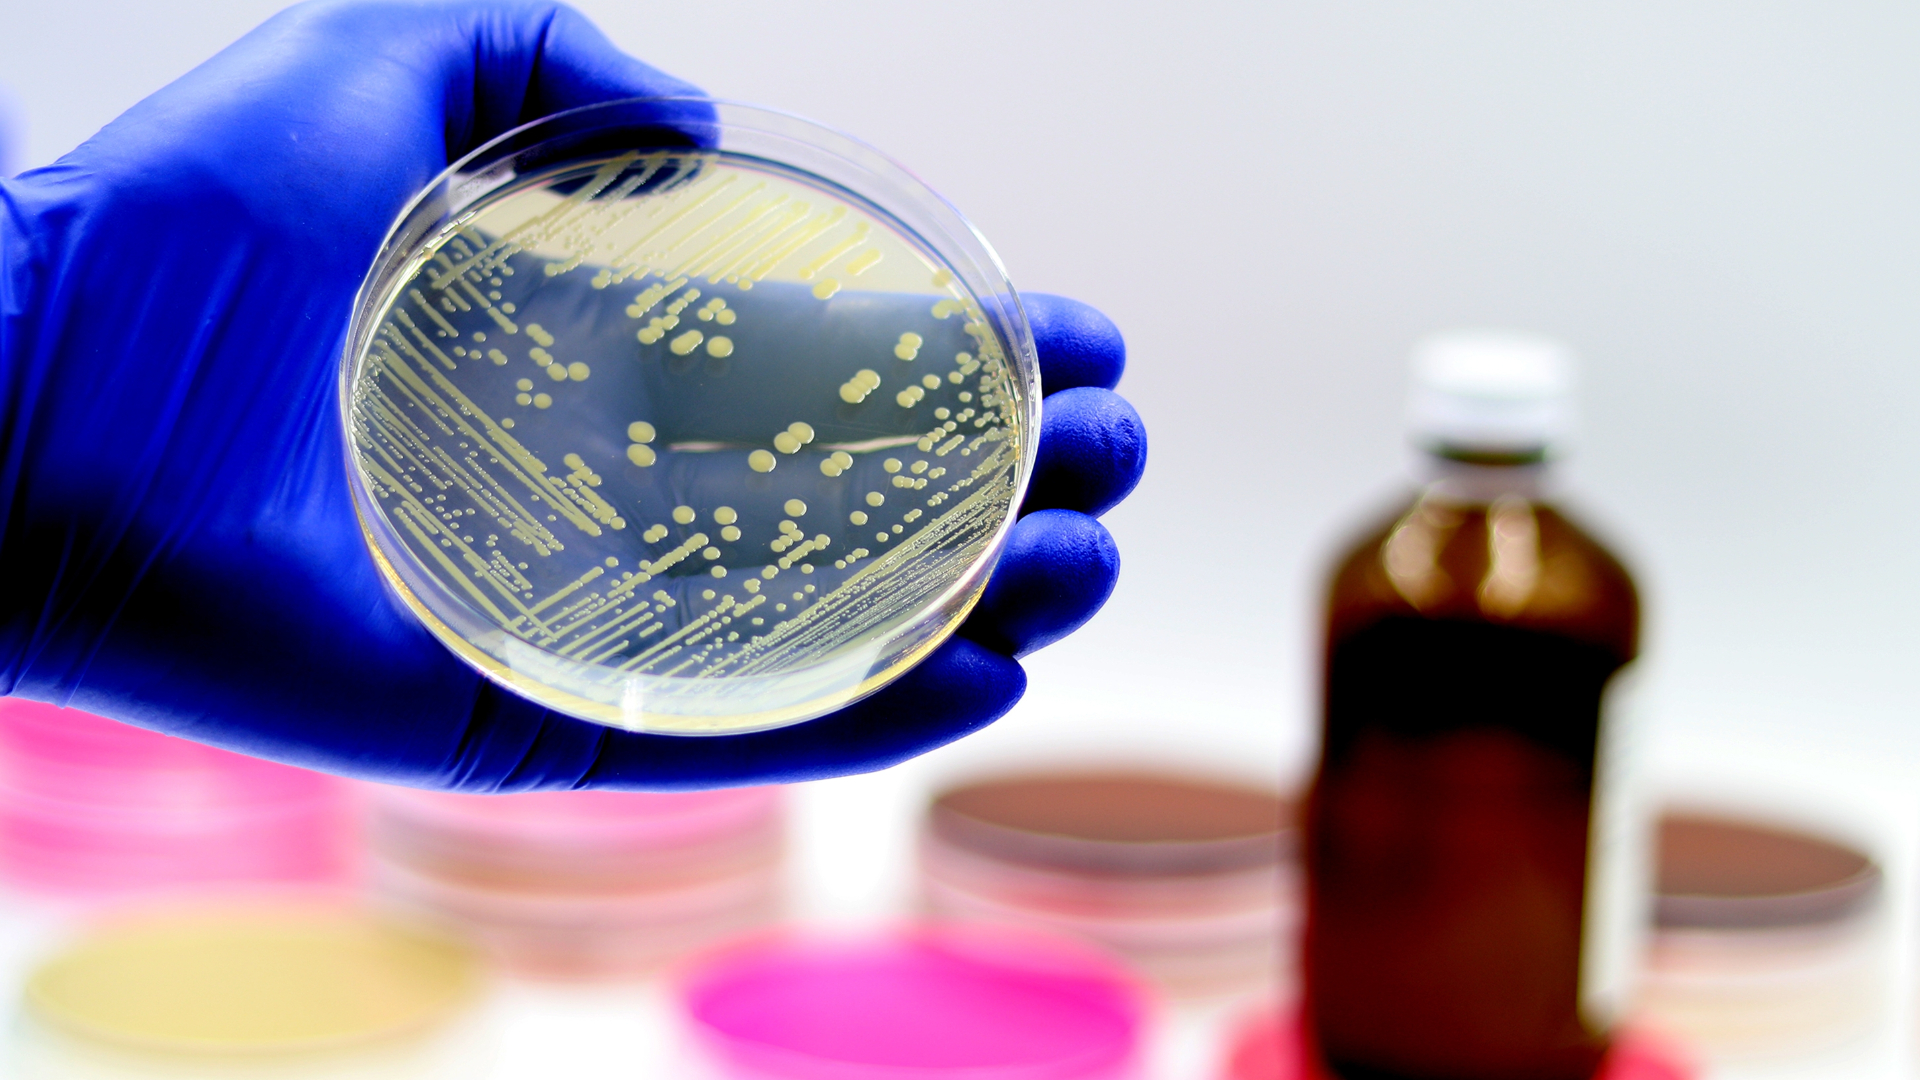

Изображения резистентного стафилококка ауреус МРСА

Раздел: Другие животные